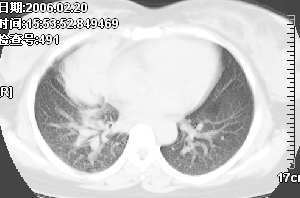

医影在线
标题: CT2844:Z肺部 [打印本页]
作者: yzt222 时间: 2006-2-25 03:22
标题: CT2844:Z肺部
(结果公布:http://www.radida.com/bbs/forum.php?mod=viewthread&tid=17538)
女,28岁咳嗽无痰偶有低烧,化验:白细胞1万零7,血沉正常

[本贴已被 jiajie 于 2006-2-25 7:26:45 修改过]
[本贴已被 翁志蓬 于 2006-11-14 13:14:25 修改过]
[本贴已被 翁志蓬 于 2007-1-3 23:48:08 修改过]
作者: yzt222 时间: 2006-2-25 03:26
第一次发图,顺序也发错了,对不起大家了。
作者: 傻子医生 时间: 2006-2-25 03:29
有没有做增强?可以把增强的片子上传吗?肺窗呢?(纵隔内好象有一淋巴结影)
作者: yzt222 时间: 2006-2-25 03:33
没有增强,做了支气管镜、病理还没有出来。
作者: 乡医 时间: 2006-2-25 03:40
图象不错,无肺窗。右肺上叶前段支气管呈鼠尾样,边缘尚光滑,气管前淋巴结肿大,未见空气支气管征考虑占位性病变可能。与大叶性肺炎和早期肺脓肿鉴别,建议抗炎后复查。
作者: doctor528 时间: 2006-2-25 03:41
应该做增强扫描
作者: zhuming943066 时间: 2006-2-25 03:45
肺窗应该有的,看来看去还是考虑炎症性东西,看看结果吧
作者: wawaquan 时间: 2006-2-25 04:05
考虑占位性病变,间质肉瘤可能大。
作者: lz8320473 时间: 2006-2-25 06:10
标题: 回复:肺部
为便于观察,帮战友把图象搬过来。

我觉得不能排除肺段炎症,建议近期治疗复查。
作者: wxy7406 时间: 2006-2-25 06:17
右肺上叶炎性病灶,建议抗炎后治疗后查.
作者: jbhaaa111 时间: 2006-2-25 06:25
考虑炎性病变
作者: aosangwa 时间: 2006-2-25 06:32
考虑间质肉瘤
作者: jiangjing 时间: 2006-2-25 08:17
右肺上叶前段与中叶见较大团块影。边界较清晰,纵隔隆突前淋巴结增大。考虑1肺部间叶组织肿瘤可能。2感染性病变
作者: lushijun 时间: 2006-2-25 14:13
右肺下叶炎性病变,治疗后复查。
作者: gaozhengyi 时间: 2006-2-25 19:46
标题: 回复:ct2844:肺部
我觉得不要把患者年龄作为轻易排除肺癌的依据,病变呈大块状软组织密度,右肺中叶支气管可见中断,右侧肺门增大,要高度警惕肺癌,支气管镜应该能够给出正确的诊断。间质来源的恶性肿瘤尽管可以考虑到,但是从发病率上来说不首先考虑。
作者: lanlan 时间: 2006-2-25 21:14
我觉得考虑感染性病变吧。结核?!
期待结果........
作者: 同 时间: 2006-2-25 21:17
考虑右肺炎性病变,建议抗炎治疗后复查。
作者: yzt222 时间: 2006-2-25 21:57
今天上午病理结果出来了:柱状上皮细胞炎性坏死。未见瘤细胞(我没有见到病理单,大概内容是这样)
药敏试验:未见致病菌。
现在病人继续抗炎治疗。等复查后再上传片子。
作者: lyfyf 时间: 2006-2-25 23:04
占位?
作者: ssl1_1 时间: 2006-2-27 01:28
高度警惕,前年我诊断的一个病例影象及症状和该病人差不多,是男的,32 岁,小细胞肺癌.
作者: jinguoji 时间: 2006-11-14 08:14
考虑右肺炎性病灶,建议抗炎治疗后复查.
作者: yzt222 时间: 2006-11-14 16:27
已经手术结果为淋巴瘤
作者: dyqct 时间: 2006-11-14 19:16
异病同影,从影像上难以做出确切的诊断。
作者: 无泪之城 时间: 2006-11-15 06:29
非常好的病例,中青年患者应该想到淋巴瘤
作者: guduchunmeng 时间: 2006-11-15 06:34
纵隔内淋巴结肿大不是非常明显。但肺部征象明显。还是第一次见到。学习了!!!!!
作者: yzt222 时间: 2007-2-24 01:31
补充病例结果是:肺间变大t细胞淋巴瘤. 非霍奇金淋巴瘤(间变大t细胞性)iv期bipi 2分
右肺中下叶切除
作者: zxczxc 时间: 2010-8-10 18:49
右肺中叶炎症。
| 欢迎光临 医影在线 (http://bbs.radida.com/bbs/) |
Powered by Discuz! X3.2 |